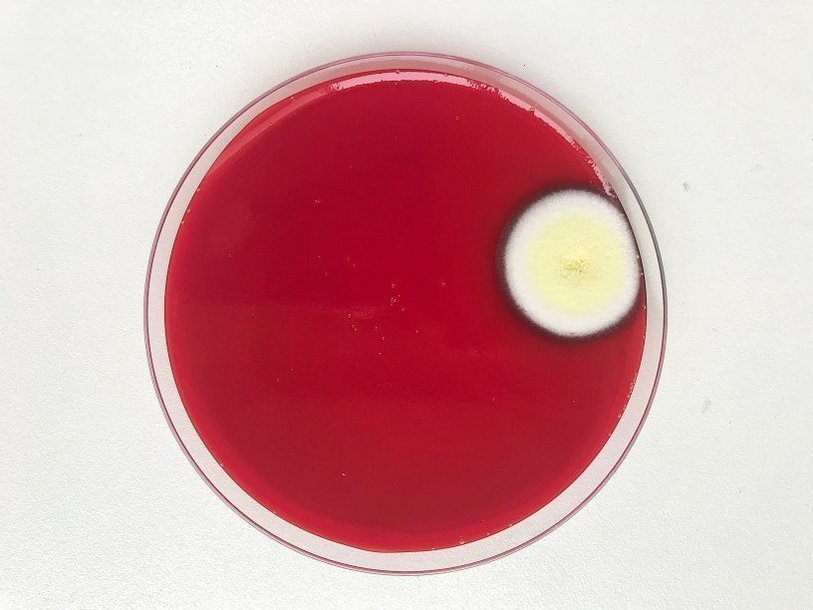

Екатерина Беленко: Промикробы: В споре рождается истина
Фото: Екатерина Беленко
Фото: Екатерина Беленко В бактериологических лабораториях есть деление на «чистую» и «грязную» зоны. В чистой зоне происходит приготовление и розлив питательных сред, а в грязной — посевы биоматериалов всех мастей, работа с уже выросшими микроорганизмами и утилизация отходов. Думаю, это вполне очевидно, что мы не выбрасываем чашки Петри просто в мусор. Мы их сначала автоклавируем, то есть убиваем всех чашечных жильцов, а уже только потом их трупики отправляются в мусор.
Но даже при таком делении на две зоны невозможно создать абсолютнейшую стерильность в зоне приготовления питательных сред. У нас нет такого тамбура, как показывают в кино, где бы специальный воздух со всех сторон обдувал человека, или еще чего-либо столь же фантастического. Поэтому время от времени, несмотря на все принятые меры, на чашках со свеженькой средой появляются незваные гости. Как, например, этот красавчик на фотографии, которого я окрестила Яишенка. Яишенка, безусловно, тоже закончил свою жизнь в автоклаве.
Кроме плесеней, случаются незваные споровые гости. Сразу хочу вас удивить: споры у микробов и споры, например, у грибов — это две разные штуки. Для грибов это способ размножения, попытка расселить своих детишек максимально эффективно. У бактерий же споры никак не связаны с размножением. У них это лишь метод пережить черную полосу. Почувствовал микробик, что дела плохи, кушать нечего и условия портятся, — побежал спору делать.
Когда бактериальная клетка становится эндоспорой, внутри нее все физиологические процессы замирают. Она становится чрезвычайно резистентной к неблагоприятным условиям окружающей среды и может сохранять жизнеспособность в течение длительного времени. Эндоспоры обладают высокой устойчивостью к высушиванию, действию химических агентов, высокой температуры и других неблагоприятных факторов. Высокая резистентность связана с большим содержанием кальциевой соли дипиколиновой кислоты в оболочке спор.
В состоянии гиперанабиоза (опять что-то киношное — из фильмов про далекие космические путешествия) споры могут сохранять жизнеспособность на протяжении огромного периода времени. Так, эндоспоры сибирской язвы в скотомогильниках сохраняют жизнеспособность в течение 500 лет, споры актиномицетов — до 7500 лет! Споры некоторых бактерий выдерживают даже кипячение в течение часа и более, поэтому растворы и инструменты стерилизуют в автоклавах с температурами стерилизации до 121 °C.
Расположение эндоспор внутри материнской клетки может быть различным, поэтому тип спорообразования в некоторых случаях используют при идентификации неизвестной культуры. Иногда формирующаяся эндоспора достигает таких размеров, что расширяет клетку посередине или с одного из концов, что прекрасно видно при микроскопии. При наступлении благоприятных условий эндоспора, как ни в чем не бывало, превращается в нормальную клетку. Всем бы нам такую отходчивость.
Смотрите также: Екатерина Беленко Промикробы: Жгутик — не роскошь Екатерина Беленко Промикробы: Зона комфорта Екатерина Беленко Промикробы: По грибы да по ягоды Екатерина Беленко Промикробы: Красная и синяя таблетки